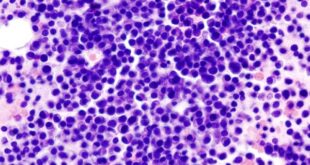

La importancia del diagnóstico oportuno de Mieloma Múltiple
Hematología.mx.- De acuerdo con el doctor Álvaro Cabrera García, médico adscrito al servicio de hematología del Hospital Regional de Alta especialidad de Ixtapaluca, es fundamental que los pacientes con Mieloma Múltiple (MM) puedan ser diagnosticados en las primeras etapas, ya que esto permite una mejor atención de la enfermedad. Este padecimiento es un cáncer hematológico … Sigue leyendo La importancia del diagnóstico oportuno de Mieloma Múltiple